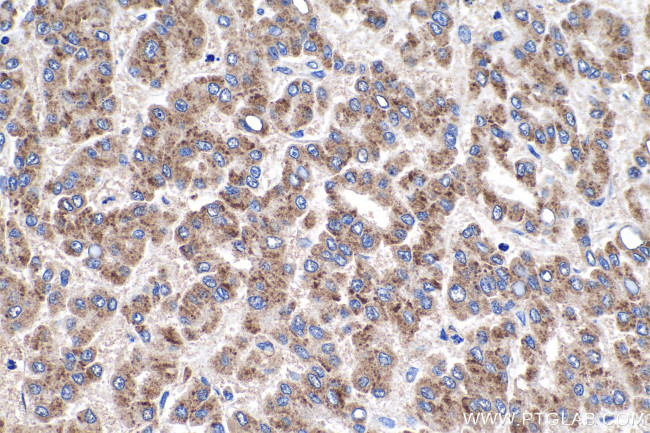
ULBP2 Antibody in Immunohistochemistry (Paraffin) (IHC (P))

Search
Proteintech
ULBP2 Polyclonal Antibody
{{$productOrderCtrl.translations['antibody.pdp.commerceCard.promotion.promotions']}}
{{$productOrderCtrl.translations['antibody.pdp.commerceCard.promotion.viewpromo']}}
{{$productOrderCtrl.translations['antibody.pdp.commerceCard.promotion.promocode']}}: {{promo.promoCode}} {{promo.promoTitle}} {{promo.promoDescription}}. {{$productOrderCtrl.translations['antibody.pdp.commerceCard.promotion.learnmore']}}
产品信息
13133-1-AP
种属反应
宿主/亚型
分类
类型
抗原
偶联物
形式
浓度
规格
纯化类型
保存液
内含物
保存条件
运输条件
产品详细信息
Immunogen sequence: AGRADPHSL CYDITVIPKF RPGPRWCAVQ GQVDEKTFLH YDCGNKTVTP VSPLGKKLNV TTAWKAQNPV LREVVDILTE QLRDIQLENY TPKEPLTLQA RMSCEQKAEG HSSGSWQFSF DGQIFLLFDS EKRMWTTVHP GARKMKEKWE NDKVVAMSFH YFSMGDCIGW LEDFLMGMDS TLEPSAGAPL AMSSGTTQLR A (25-224 aa encoded by BC034689)
靶标信息
ULBP2 encodes a major histocompatibility complex (MHC) class I-related molecule that binds to the NKG2D receptor on natural killer (NK) cells to trigger release of multiple cytokines and chemokines that in turn contribute to the recruitment and activation of NK cells. The encoded protein undergoes further processing to generate the mature protein that is either anchored to membrane via a glycosylphosphatidylinositol moiety, or secreted. Many malignant cells secrete the encoded protein to evade immunosurveillance by NK cells. This gene is located in a cluster of multiple MHC class I-related genes on chromosome 6.
仅用于科研。不用于诊断过程。未经明确授权不得转售。
生物信息学
蛋白别名: ALCAN-alpha; N2DL-2; N2DL2; NKG2D ligand 2; Retinoic acid early transcript 1H; retinoic acid early transcript 1L; UL16-binding protein 2; unnamed protein product
基因别名: ALCAN-alpha; N2DL2; NKG2DL2; RAET1H; RAET1L; ULBP2; UNQ463/PRO791
UniProt ID: (Human) Q9BZM5
Entrez Gene ID: (Human) 80328